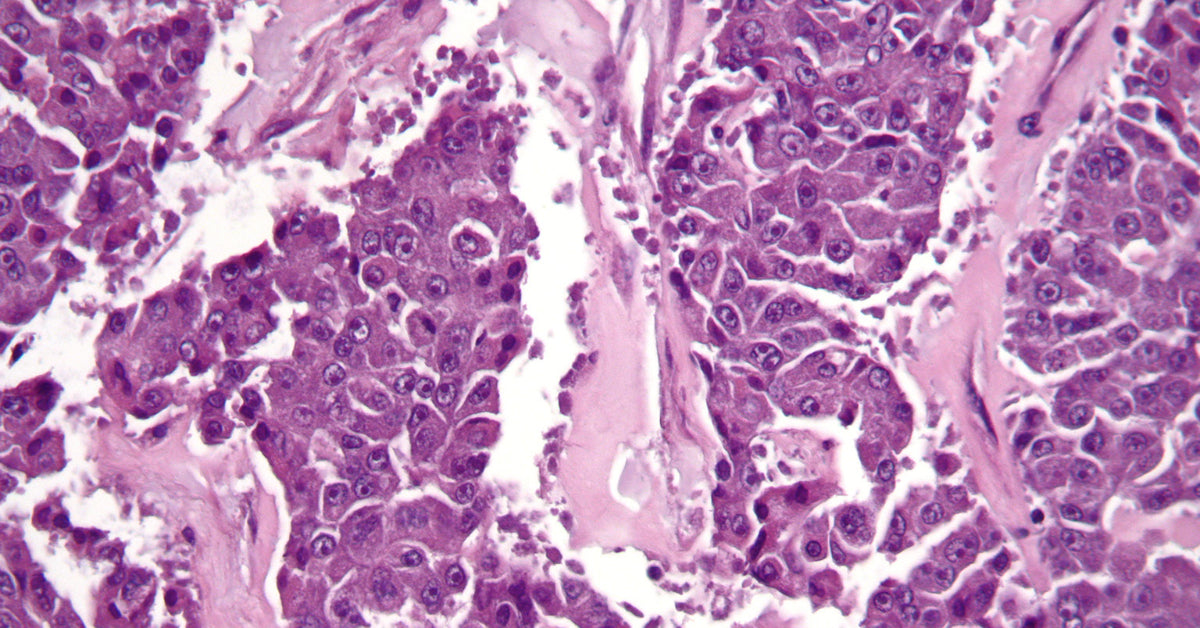

In honor of Pancreatic Cancer Awareness Month in November, I've teamed up with the Pancreatic Cancer Action Network (PanCAN) to bring you a brand new design that raises money to fund their programs & help push research towards a cure forward. I'm so excited about this brand new design! Not only is it for an amazing cause, but it's a totally new idea too. I can't wait to tell you all about it!
Pancreatic Cancer Jewelry
Did I mention how excited I am for this new design?! It's a totally new idea and I'm kind of obsessed with it. The simple and sophisticated silhouette is perfect for wearing any time of day or night. Making it the perfect choice to spread awareness wherever you go. Keep reading to learn more about my design inspiration & how this necklace helps PanCAN!
Pin it for Later

Looking for tips on how to navigate the Covid-19 situation with Pancreatic Cancer? Click here to watch an interview with an expert.
Design Inspiration
When I sat down to create this necklace style, I knew I wanted to do something totally different. I'd been playing around with the idea of getting rid of the metal bezels (the cups that hold the image and resin in my other designs) and just using the cell images and resin. I knew it had to be possible, but I definitely had to go through a few (or many) trials and attempts before I got it perfect!
I started with this cell image, or histology slide, of Pancreatic Cancer. As a side note, I'm glad this image comes in purple because it's the awareness color for pancreatic cancer.

Introducing the Life Saver Necklace for Pancreatic Cancer Awareness
The Life Saver Necklace for Pancreatic Cancer Awareness acts like a metaphorical buoy, keeping you afloat when you feel like everything around you is too much to handle. Wear this necklace as a symbol of your loved one's support and encouragement to carry on with grace.
This necklace features an adjustable sterling silver or 14k gold filled chain that can be worn at any length from 16-18 inches. The large round pendant is a cutout from a Pancreatic Cancer cell image coated in resin. A lobster clasp makes sure this chain will stay on all day long.
For each necklace you purchase, you're literally a "life saver" because 10% of proceeds is donated to the Pancreatic Cancer Action Network to help them double the survival rate.
Get Yours Now
Perfect timing for the holidays, these necklaces are on sale now! Click below to order yours now.

Leave a comment